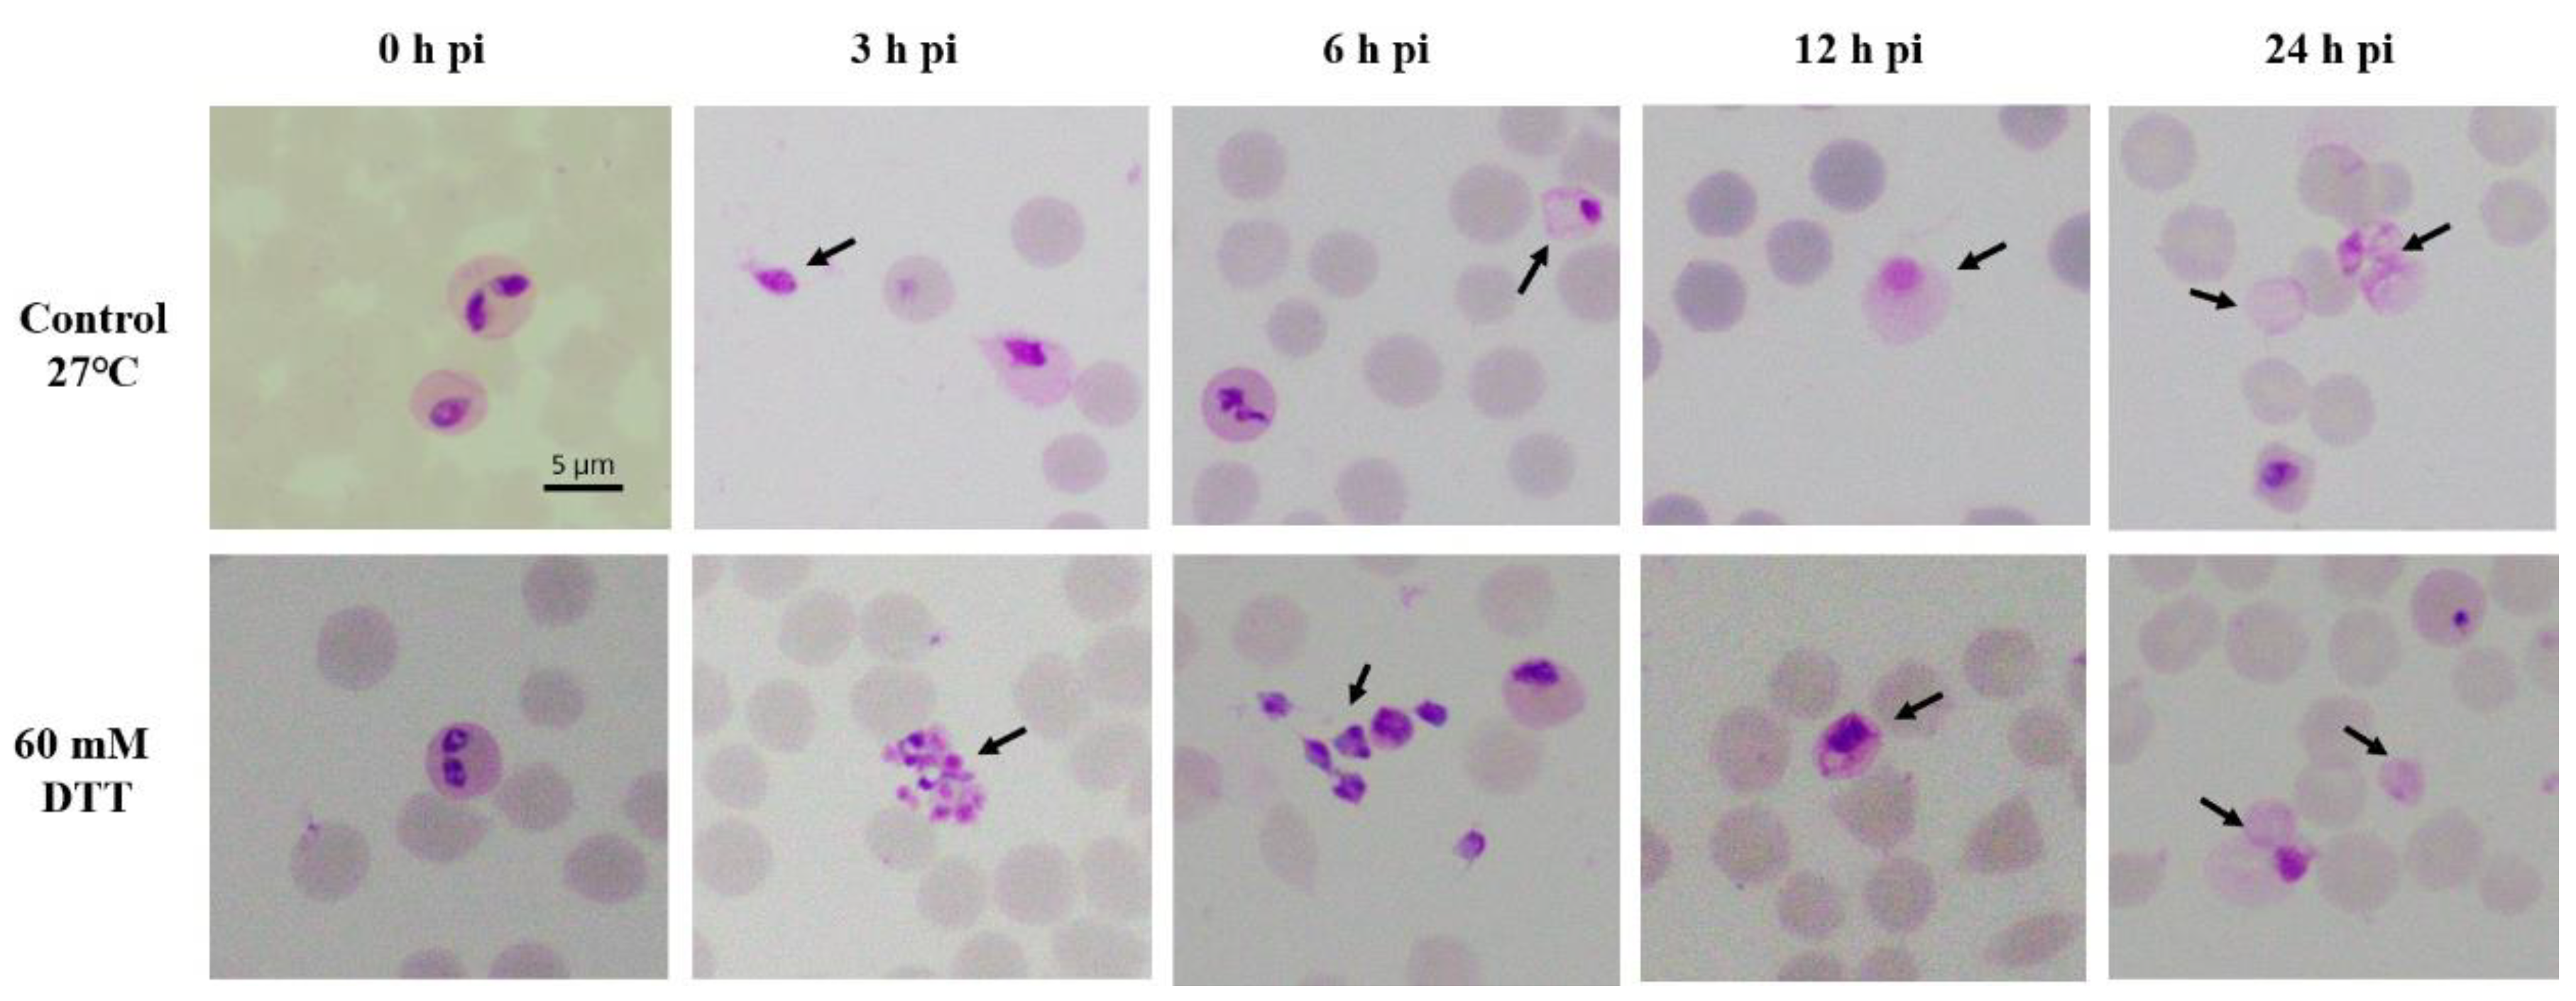
Pathogens 08 00104 g001 550

Initiated Babesia ovata Sexual Stages under In Vitro Conditions Were Recognized by Anti-CCp2 Antibodies, Showing Changes in the DNA Content by Imaging Flow Cytometry
Abstract
:1. Introduction
2. Results
2.1. Development of B. ovata Tick Stages under In Vitro Induction
2.2. B. ovata Tick Stages Induced under In Vitro Conditions Were Recognized by Sexual-Stage-Specific Anti-Ccp2 Antibody
2.3. Measuring DNA Content in B. ovata Tick Stages
3. Discussion
4. Materials and Methods
4.1. In Vitro Induction of B. ovata Tick Stages
4.2. Synthetic Peptides and Antisera
4.3. Immunofluorescence Assays
4.4. Imaging Flow Cytometry Analysis of B. ovata Tick Stages
Supplementary Materials
Author Contributions
Funding
Conflicts of Interest
References
- Ristic, M.; McIntyre, I. Diseases of Cattle in the Tropics: Economic and Zoonotic Relevance; Springer: Berlin/Heidelberg, Germany, 1981; p. xii. 662p. [Google Scholar]
- Schnittger, L.; Rodriguez, A.E.; Florin-Christensen, M.; Morrison, D.A. Babesia: A world emerging. Infect. Genet. Evol. 2012, 12, 1788–1809. [Google Scholar] [CrossRef] [PubMed]
- Uilenberg, G. International collaborative research: Significance of tick-borne hemoparasitic diseases to world animal health. Vet. Parasitol. 1995, 57, 19–41. [Google Scholar] [CrossRef]
- Bock, R.; Jackson, L.; de Vos, A.; Jorgensen, W. Babesiosis of cattle. Parasitology 2004, 129, S247–S269. [Google Scholar] [CrossRef] [PubMed]
- Sivakumar, T.; Igarashi, I.; Yokoyama, N. Babesia ovata: Taxonomy, phylogeny and epidemiology. Vet. Parasitol. 2016, 229, 99–106. [Google Scholar] [CrossRef] [PubMed]
- Gray, J.S.; Estrada-Pena, A.; Zintl, A. Vectors of babesiosis. Annu. Rev. Entomol. 2019, 64, 149–165. [Google Scholar] [CrossRef] [PubMed]
- Gough, J.M.; Jorgensen, W.K.; Kemp, D.H. Development of tick gut forms of Babesia bigemina in vitro. J. Eukaryot. Microbiol. 1998, 45, 298–306. [Google Scholar] [PubMed]
- Mosqueda, J.; Falcon, A.; Antonio Alvarez, J.; Alberto Ramos, J.; Oropeza-Hernandez, L.F.; Figueroa, J.V. Babesia bigemina sexual stages are induced in vitro and are specifically recognized by antibodies in the midgut of infected boophilus microplus ticks. Int. J. Parasitol. 2004, 34, 1229–1236. [Google Scholar] [CrossRef] [PubMed]
- Hussein, H.E.; Bastos, R.G.; Schneider, D.A.; Johnson, W.C.; Adham, F.K.; Davis, W.C.; Laughery, J.M.; Herndon, D.R.; Alzan, H.F.; Ueti, M.W.; et al. The Babesia bovis hap2 gene is not required for blood stage replication, but expressed upon in vitro sexual stage induction. PLoS Neglect. Trop. Dis. 2017, 11, e0005965. [Google Scholar] [CrossRef] [PubMed]
- Bohaliga, G.A.R.; Johnson, W.C.; Taus, N.S.; Hussein, H.E.; Bastos, R.G.; Suarez, C.E.; O’Connor, R.; Ueti, M.W. Identification of a putative methyltransferase gene of Babesia bigemina as a novel molecular biomarker uniquely expressed in parasite tick stages. Paras. Vect. 2018, 11, 480. [Google Scholar] [CrossRef] [PubMed]
- Maeda, H.; Hatta, T.; Alim, M.A.; Tsubokawa, D.; Mikami, F.; Kusakisako, K.; Matsubayashi, M.; Umemiya-Shirafuji, R.; Tsuji, N.; Tanaka, T. Initial development of Babesia ovata in the tick midgut. Vet. Parasitol. 2017, 233, 39–42. [Google Scholar] [CrossRef] [PubMed]
- Bastos, R.G.; Suarez, C.E.; Laughery, J.M.; Johnson, W.C.; Ueti, M.W.; Knowles, D.P. Differential expression of three members of the multidomain adhesion ccp family in Babesia bigemina, Babesia bovis and Theileria equi. PLoS ONE 2013, 8, e67765. [Google Scholar] [CrossRef] [PubMed]
- Becker, C.A.; Malandrin, L.; Depoix, D.; Larcher, T.; David, P.H.; Chauvin, A.; Bischoff, E.; Bonnet, S. Identification of three ccp genes in Babesia divergens: Novel markers for sexual stages parasites. Mol. Biochem. Parasitol. 2010, 174, 36–43. [Google Scholar] [CrossRef] [PubMed]
- Higuchi, S.; Ezura, K.; Hamana, M.; Kawamura, S.; Yasuda, Y. Development of Babesia ovata in the midgut of the tick, haemaphysalis longicornis. Nihon juigaku zasshi. Jpn. J. Vet. Sci. 1989, 51, 1129–1135. [Google Scholar] [CrossRef]
- Mackenstedt, U.; Gauer, M.; Fuchs, P.; Zapf, F.; Schein, E.; Mehlhorn, H. DNA measurements reveal differences in the life cycles of Babesia bigemina and B. canis, two typical members of the genus babesia. Parasitol. Res. 1995, 81, 595–604. [Google Scholar] [CrossRef] [PubMed]
- Mackenstedt, U.; Gauer, M.; Mehlhorn, H.; Schein, E.; Hauschild, S. Sexual cycle of Babesia divergens confirmed by DNA measurements. Parasitol. Res. 1990, 76, 199–206. [Google Scholar] [CrossRef] [PubMed]
- Jalovecka, M.; Hajdusek, O.; Sojka, D.; Kopacek, P.; Malandrin, L. The complexity of piroplasms life cycles. Front. Cell. Infect. Microbiol. 2018, 8, 248. [Google Scholar] [CrossRef] [PubMed]
- Hakimi, H.; Yamagishi, J.; Kegawa, Y.; Kaneko, O.; Kawazu, S.; Asada, M. Establishment of transient and stable transfection systems for Babesia ovata. Paras. Vect. 2016, 9, 171. [Google Scholar] [CrossRef] [PubMed]
- Igarashi, I.; Avarzed, A.; Tanaka, T.; Inoue, N.; Ito, M.; Omata, Y.; Saito, A.; Suzuki, N. Continuous in vitro cultivation of Babesia ovata. J. Protozool. Res. 1994, 111–118. [Google Scholar]
- Yamagishi, J.; Asada, M.; Hakimi, H.; Tanaka, T.Q.; Sugimoto, C.; Kawazu, S.I. Whole-genome assembly of Babesia ovata and comparative genomics between closely related pathogens. BMC Genomics 2017, 18, 832. [Google Scholar] [CrossRef] [PubMed]

| B. ovata | 0 h | 3 h | 6 h | 9 h | 12 h | 24 h | 48 h | 72 h |
|---|---|---|---|---|---|---|---|---|
| Parasitemia (%) | 4.50 ± 0.40 | 3.50 ± 0.00 | 3.00 ± 0.00 | 2.10 ± 0.10 | 1.90 ± 0.15 | 1.20 ± 0.10 | 0.50 ± 0.00 | 0.40 ± 0.20 |
| Free merozoites (%) | 0.19 ± 0.01 | 1.40± 0.00 * | 1.40± 0.00 | 0.35 ± 0.03 | 0.40 ± 0.00 | 0.25 ± 0.03 | 0.10 ± 0.00 | - |
| Aggregation forms (%) | - | 0.07± 0.00 | - | - | - | - | 0.03 ± 0.00 | - |
| Gametocytes ** (%) | - | - | 0.20 ± 0.00 | 0.10 ± 0.00 | 0.30 ± 0.10 | 0.6± 0.1 | 0.10 ± 0.00 | - |
| Zygotes *** (%) | - | - | - | 0.18 ± 0.00 | 0.4 ± 0.1 | 0.75 ± 0.2 | 4.00± 0.10 | 2.00 ± 0.00 |
| 12 h pi | 48 h pi | |
|---|---|---|
| R3 | 16,680 (73.9%) | 27,428 (60.3%) |
| R4 | 4709 (20.9%) | 14,603 (32.1%) |
| R5 | 1174 (5.2%) | 3447 (7.6%) |
© 2019 by the authors. Licensee MDPI, Basel, Switzerland. This article is an open access article distributed under the terms and conditions of the Creative Commons Attribution (CC BY) license (http://creativecommons.org/licenses/by/4.0/).
Share and Cite
Nguyen, T.-T.; Dang-Trinh, M.-A.; Higuchi, L.; Mosqueda, J.; Hakimi, H.; Asada, M.; Yamagishi, J.; Umemiya-Shirafuji, R.; Kawazu, S.-i. Initiated Babesia ovata Sexual Stages under In Vitro Conditions Were Recognized by Anti-CCp2 Antibodies, Showing Changes in the DNA Content by Imaging Flow Cytometry. Pathogens 2019, 8, 104. https://doi.org/10.3390/pathogens8030104
Nguyen T-T, Dang-Trinh M-A, Higuchi L, Mosqueda J, Hakimi H, Asada M, Yamagishi J, Umemiya-Shirafuji R, Kawazu S-i. Initiated Babesia ovata Sexual Stages under In Vitro Conditions Were Recognized by Anti-CCp2 Antibodies, Showing Changes in the DNA Content by Imaging Flow Cytometry. Pathogens. 2019; 8(3):104. https://doi.org/10.3390/pathogens8030104
Chicago/Turabian StyleNguyen, Thu-Thuy, Minh-Anh Dang-Trinh, Luna Higuchi, Juan Mosqueda, Hassan Hakimi, Masahito Asada, Junya Yamagishi, Rika Umemiya-Shirafuji, and Shin-ichiro Kawazu. 2019. "Initiated Babesia ovata Sexual Stages under In Vitro Conditions Were Recognized by Anti-CCp2 Antibodies, Showing Changes in the DNA Content by Imaging Flow Cytometry" Pathogens 8, no. 3: 104. https://doi.org/10.3390/pathogens8030104
APA StyleNguyen, T.-T., Dang-Trinh, M.-A., Higuchi, L., Mosqueda, J., Hakimi, H., Asada, M., Yamagishi, J., Umemiya-Shirafuji, R., & Kawazu, S.-i. (2019). Initiated Babesia ovata Sexual Stages under In Vitro Conditions Were Recognized by Anti-CCp2 Antibodies, Showing Changes in the DNA Content by Imaging Flow Cytometry. Pathogens, 8(3), 104. https://doi.org/10.3390/pathogens8030104

